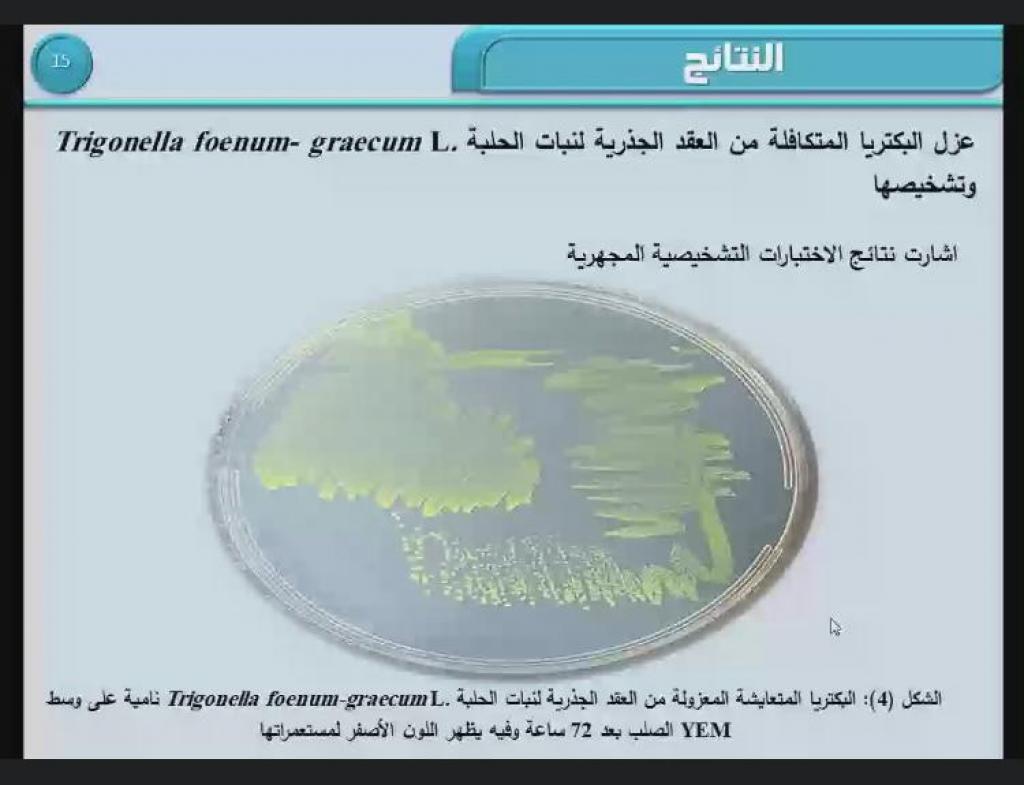

24 أغسطس، 2021
حلقات دراسية لطلبة الدراسات العليا / قسم علوم الحياة

ضمن سلسلة النشاطات العلمية لقسم علوم الحياة وبحضور السيد رئيس القسم الأستاذ المساعد الدكتور رائد سالم الصفار القى طالب الماجستير ( زيد تحسين ) حلقة دراسية عن رسالته الموسومة ” دراسة جزيئية لبكتريا العقد الجذرية لنبات الحلبة Trigonella foenum graecum L. ونقل بلازميداتها إلى بكتريا Eschercichia coli وAgrobacterium tumefaciens والتحري عن كفاءتهم في تكوين العلاقة التكافلية مع نبات البرسيم ” بإشراف أ.د. أمجد عبد الهادي .كما القى طالب الماجستير ( مصطفى طه دحام ) حلقة دراسية عن رسالته الموسومة ” دراسة وراثية و فسلجية لعدد من الجينات المضادة للأكسدة وتحديد علاقتها مع حالات العقم لدى الرجال في مدينة الموصل ” بأشراف ا. م. د. أويس موفق .وذلك في تمام الساعة التاسعة من مساء يوم الإثنين الموافق 23 آب 2021مع تمنياتنا لطلبتنا الأعزاء دوام الموفقية والنجاح.